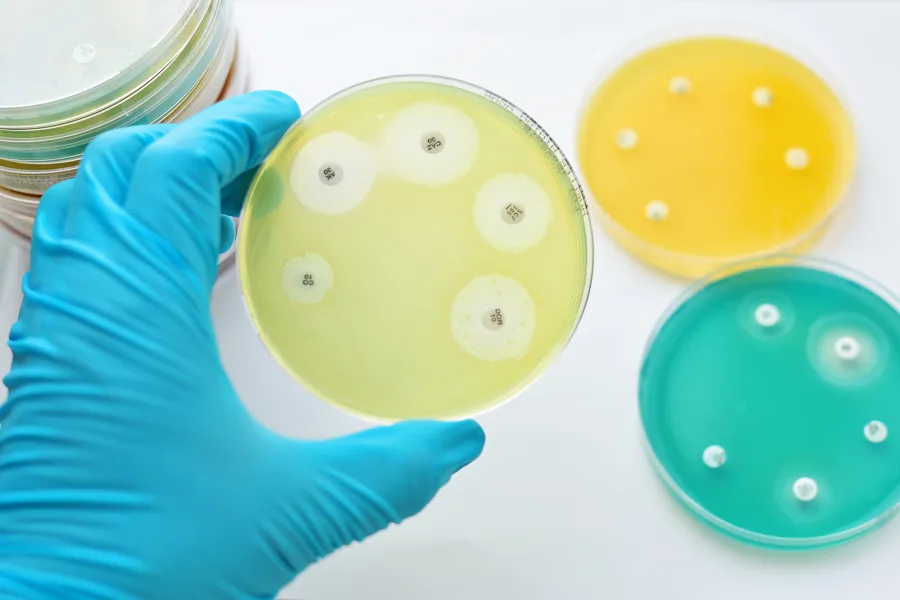
En person som holder en dyrkningsskål

NordicAST med ny oversikt over betalaktamaseinhibitorer
Publisert 20.11.2025
Foto: ECDC
Nordic Committee on Antimicrobial Susceptibility Testing (NordicAST) har publisert et dokument som viser forventet effekt av betalaktamaseinhibitorer (BLI) alene, samt kombinasjoner av betalaktamantibiotika med betalaktamaseinhibitorer (BLBLI) og cefiderocol.
Oversikten gjelder ulike betalaktamaser som påvirker følsomheten for betalaktamer hos gramnegative bakterier (Enterobacterales, Pseudomonas spp. og Acinetobacter baumannii-gruppen).
Dokumentet finner du her: NordicAST BL-BLI